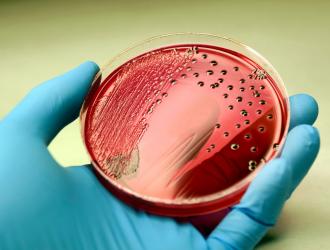

Un gruppo di ricercatori del Dipartimento di Oncologia Sperimentale dell’Istituto Europeo di Oncologia, coordinati da Federica Facciotti e Francesco Strati, ha scoperto che alcune terapie antibiotiche ad ampio spettro, come vancomicina e streptomicina, ...
antibiotici
La cistite è un disturbo di cui soffre una donna su due, ma si evidenzia un eccessivo utilizzo di antibiotici: in questo modo si rischia l'inefficacia.
A sottolinearlo è la Fondazione Italiana Continenza (FIC), che ha presentato un documento che integra le linee guida di trattamento....
Tutti sanno cos'è l’appendicite, per averlo letto o per averne avuta esperienza diretta in famiglia o perché capitata a qualche amico. Dal punto di vista medico è un’infiammazione acuta dell’appendice (una formazione tubolare, vermiforme che fa parte dell’intestino crasso) e...
La medicina potrebbe avere presto una nuova arma per la lotta ai batteri resistenti agli antibiotici. L'uso di oligonucleotidi, brevi molecole di acidi nucleici, potrebbe infatti nuovamente renderli sensibili e, dunque, sconfiggerli con gli stessi antibiotici.
A dirlo è un gruppo di...
Antibiotici comunemente prescritti come claritromicina ed eritromicina (e tutti gli altri appartenenti alla classe dei macrolidi) sono associati a maggior rischio di importanti difetti congeniti, ad esempio cardiaci, se assunti nei...
Eliminando il batterio dell'ulcera può più che dimezzare il rischio di tumore dello stomaco in individui con familiarità per questa malattia e quindi già di per sé ad alto rischio.
Lo rivela una sperimentazione clinica resa nota sul New England Journal of Medicine e condotta dal professor ...
Se fosse una malattia sarebbe la seconda più letale al mondo, con 7-9 milioni di morti l'anno, molti di più rispetto ad esempio ai 7-800.000 dell'HIV-AIDS.
Quella legata alla sepsi, hanno ricordato lo scorso 13 settembre gli esperti in occasione del World Sepsis Day, giornata mondiale...
Cresce l'emergenza inquinamento da antibiotici nei fiumi di tutto il mondo che in qualche caso superano i livelli di sicurezza di oltre 300 volte.
Lo afferma uno studio dell'Università di New York che è stato presentato al meeting della Society of Environmental Toxicology and Chemistry...
Una nuova generazione di antibiotici potrebbe arrivare da molecole naturalmente presenti nell'organismo umano, come un enzima che aiuta a digerire. Queste sostanze sono infatti in grado di uccidere batteri come Salmonella ed Escherichia coli e potrebbero essere modificate per combattere i superbatteri...
Un quarto dei farmaci usati comunemente ha un effetto negativo sui batteri che vivono nell'intestino (microbioma intestinale) paragonabile a quello degli antibiotici.
Lo ha scoperto uno studio europeo pubblicato dalla rivista Nature, secondo cui questo può avere un effetto anche sul...